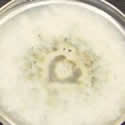
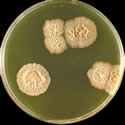

Laboratory Agar Plate Screening Tests
In the screening phase of wood protection developments, one of the oldest methods, and still widely used by development laboratories, is the agar plate screening test procedure. At the outset of a development program, this type of methodology can give initial indicative results in a simple low cost procedure.
These methods have been used for basic screening for mold, staining and decay fungi.
In the early phase testing this may involve agar plate tests directly on the agar substrate, but the limitations of this procedure in determining potential effects on wood, sometimes leads to a second phase involving the use of thin profile wood samples held above the agar base on which the pure culture fungi are grown.
Beyond use as an initial screening technique, the agar plate methods are not usually used extensively in the wood protection research field.
Images
References